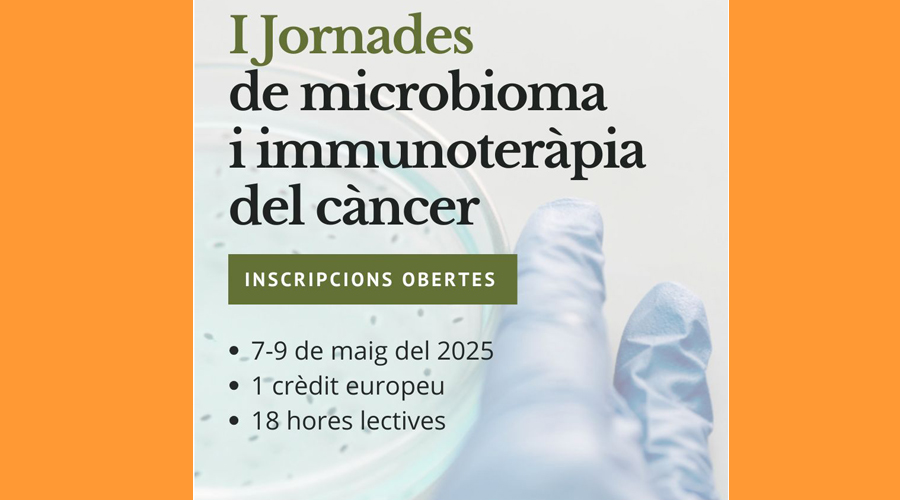
Cartell anunciador de les jornades

La microbiota i la immunoteràpia són dues àrees en constant evolució que estan revolucionant la medicina personalitzada. Per aquest motiu, el Centre de Diagnòstic Biomèdic (CDB) de l’Hospital Clínic de Barcelona – Universitat de Barcelona, la Universitat d’Andorra (UdA) i Cellab – CDMO organitzen les I Jornades de microbioma i immunoteràpia del càncer que se celebraran del 7 al 9 de maig de 2025.
La Universitat d’Andorra serà l’escenari d’aquest programa formatiu que comptarà amb la direcció acadèmica del cap de servei d’anatomia patològica, el Dr. Antonio Martínez, del cap de servei d’immunoteràpia, el Dr. Manel Juan i del cap de servei de microbiologia, el Dr. Climent Casals, de l’Hospital Clínic de Barcelona. El curs també compta amb la col·laboració del Dr. Adrià Archilla de la Universitat d’Andorra, i de la Dra. Cristina Royo i el Dr. David Vilanova, del Servei Andorrà d’Atenció Sanitària (SAAS).
Aquestes jornades tenen com a principal objectiu proporcionar als professionals sanitaris una comprensió integral sobre la interacció entre la microbiota i el sistema immune, així com les aplicacions clíniques de la immunoteràpia. Es combinaran sessions teòriques i pràctiques per a aprofundir en la composició i la funció de la microbiota en diferents parts del cos, destacant el seu paper com a immunomodulador i el seu potencial en tractaments clínics. El curs, que tindrà una durada de tres dies, farà especial èmfasi en tècniques com el trasplantament de microbiota fecal i en les possibilitats terapèutiques de la microbiota en el desenvolupament de tractaments personalitzats.
Els participants tindran l’oportunitat d’explorar tècniques avançades com la teràpia amb cèl·lules CAR-T i la combinació de diverses estratègies immunològiques per a optimitzar els resultats clínics. A més, es realitzaran pràctiques en citometria de flux per a l’anàlisi de cèl·lules immunes, oferint una experiència directa en la investigació immunològica. La part pràctica d’aquest curs es durà a terme al laboratori farmacèutic andorrà fabricant de teràpies avançades, Cellab CDMO.
El curs també inclou un enfocament en la recerca translacional, analitzant les aplicacions combinades de la microbiota i la immunoteràpia en medicina personalitzada. Els participants treballaran en equips per a desenvolupar propostes de recerca innovadores, promovent la seva capacitació en investigació científica i facilitant el seu desenvolupament professional en aquests camps emergents.
Inscripcions obertes i places limitades Les inscripcions a les I Jornades de microbioma i immunoteràpia del càncer ja es troben obertes i es poden realitzar a través de l’enllaç: https://www.uda.ad/i-jornadesde-microbioma-i-immunoterapia-del-cancer/. Les places són limitades i s’atorgaran per rigorós ordre d’inscripció.


